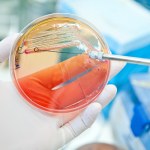
Naukowcy nie dowierzają. Superbakterie zabija cukier z… bakterii

cukier
- Wszystkie (3)
- Wiadomości (3)
Wiadomości (3)
-
Naukowcy nie dowierzają. Superbakterie zabija cukier z… bakterii
- Wtorek, 17 lutego (08:30)
-
Pijesz napoje gazowane? Czas przebadać serce. Kardiolodzy alarmują
- Piątek, 8 marca 2024 (12:56)
-
Kawa będzie coraz droższa. Unia Europejska zapowiada wielki kryzys
- Środa, 19 października 2022 (09:30)